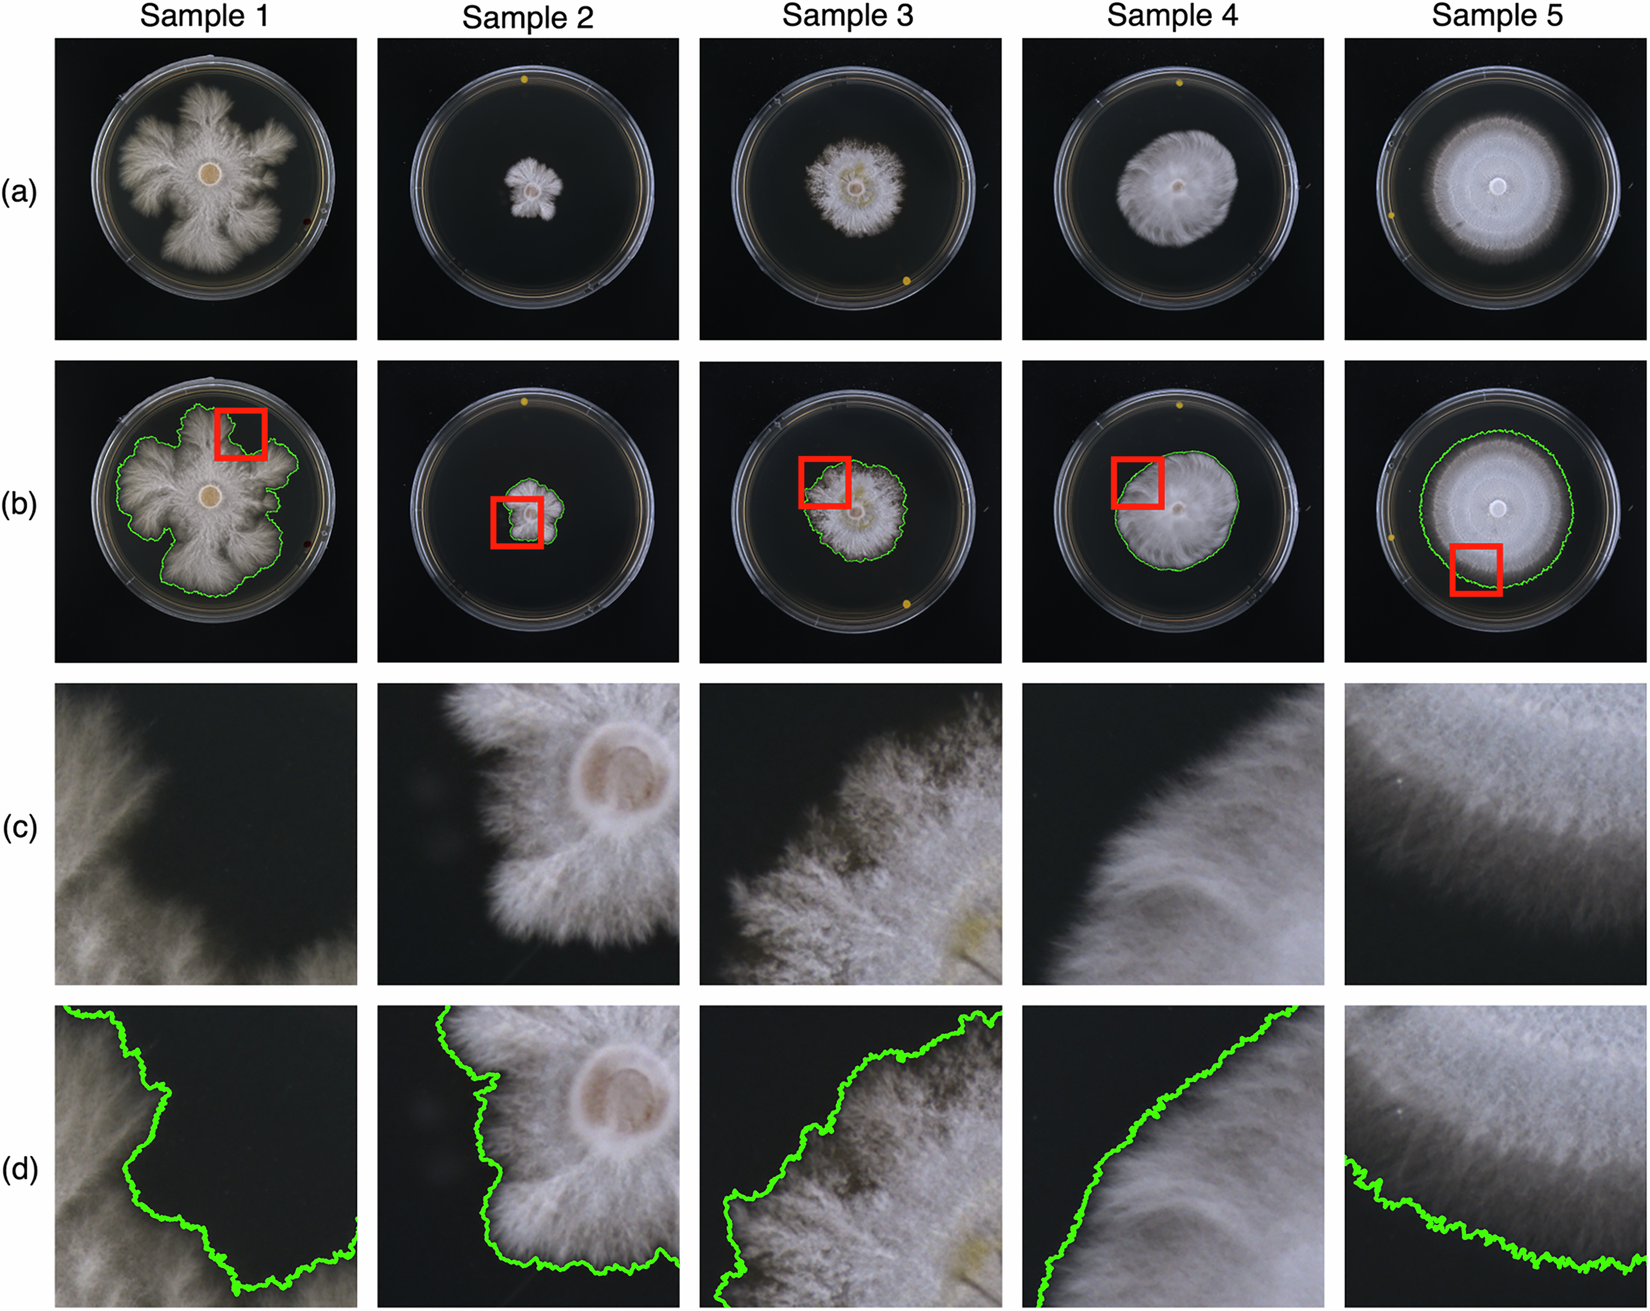
Fig. 3

Fig. 3
From: A Mycelium Dataset with Edge-Precise Annotation for Semantic Segmentation
Overview of the raw image and its annotation at global and local scales. (a) Original image. (b) Edge map of the full annotation on the original image with the magnified region indicated. (c) Magnified view of the local original image; (d) Corresponding magnified view of the annotation edge.